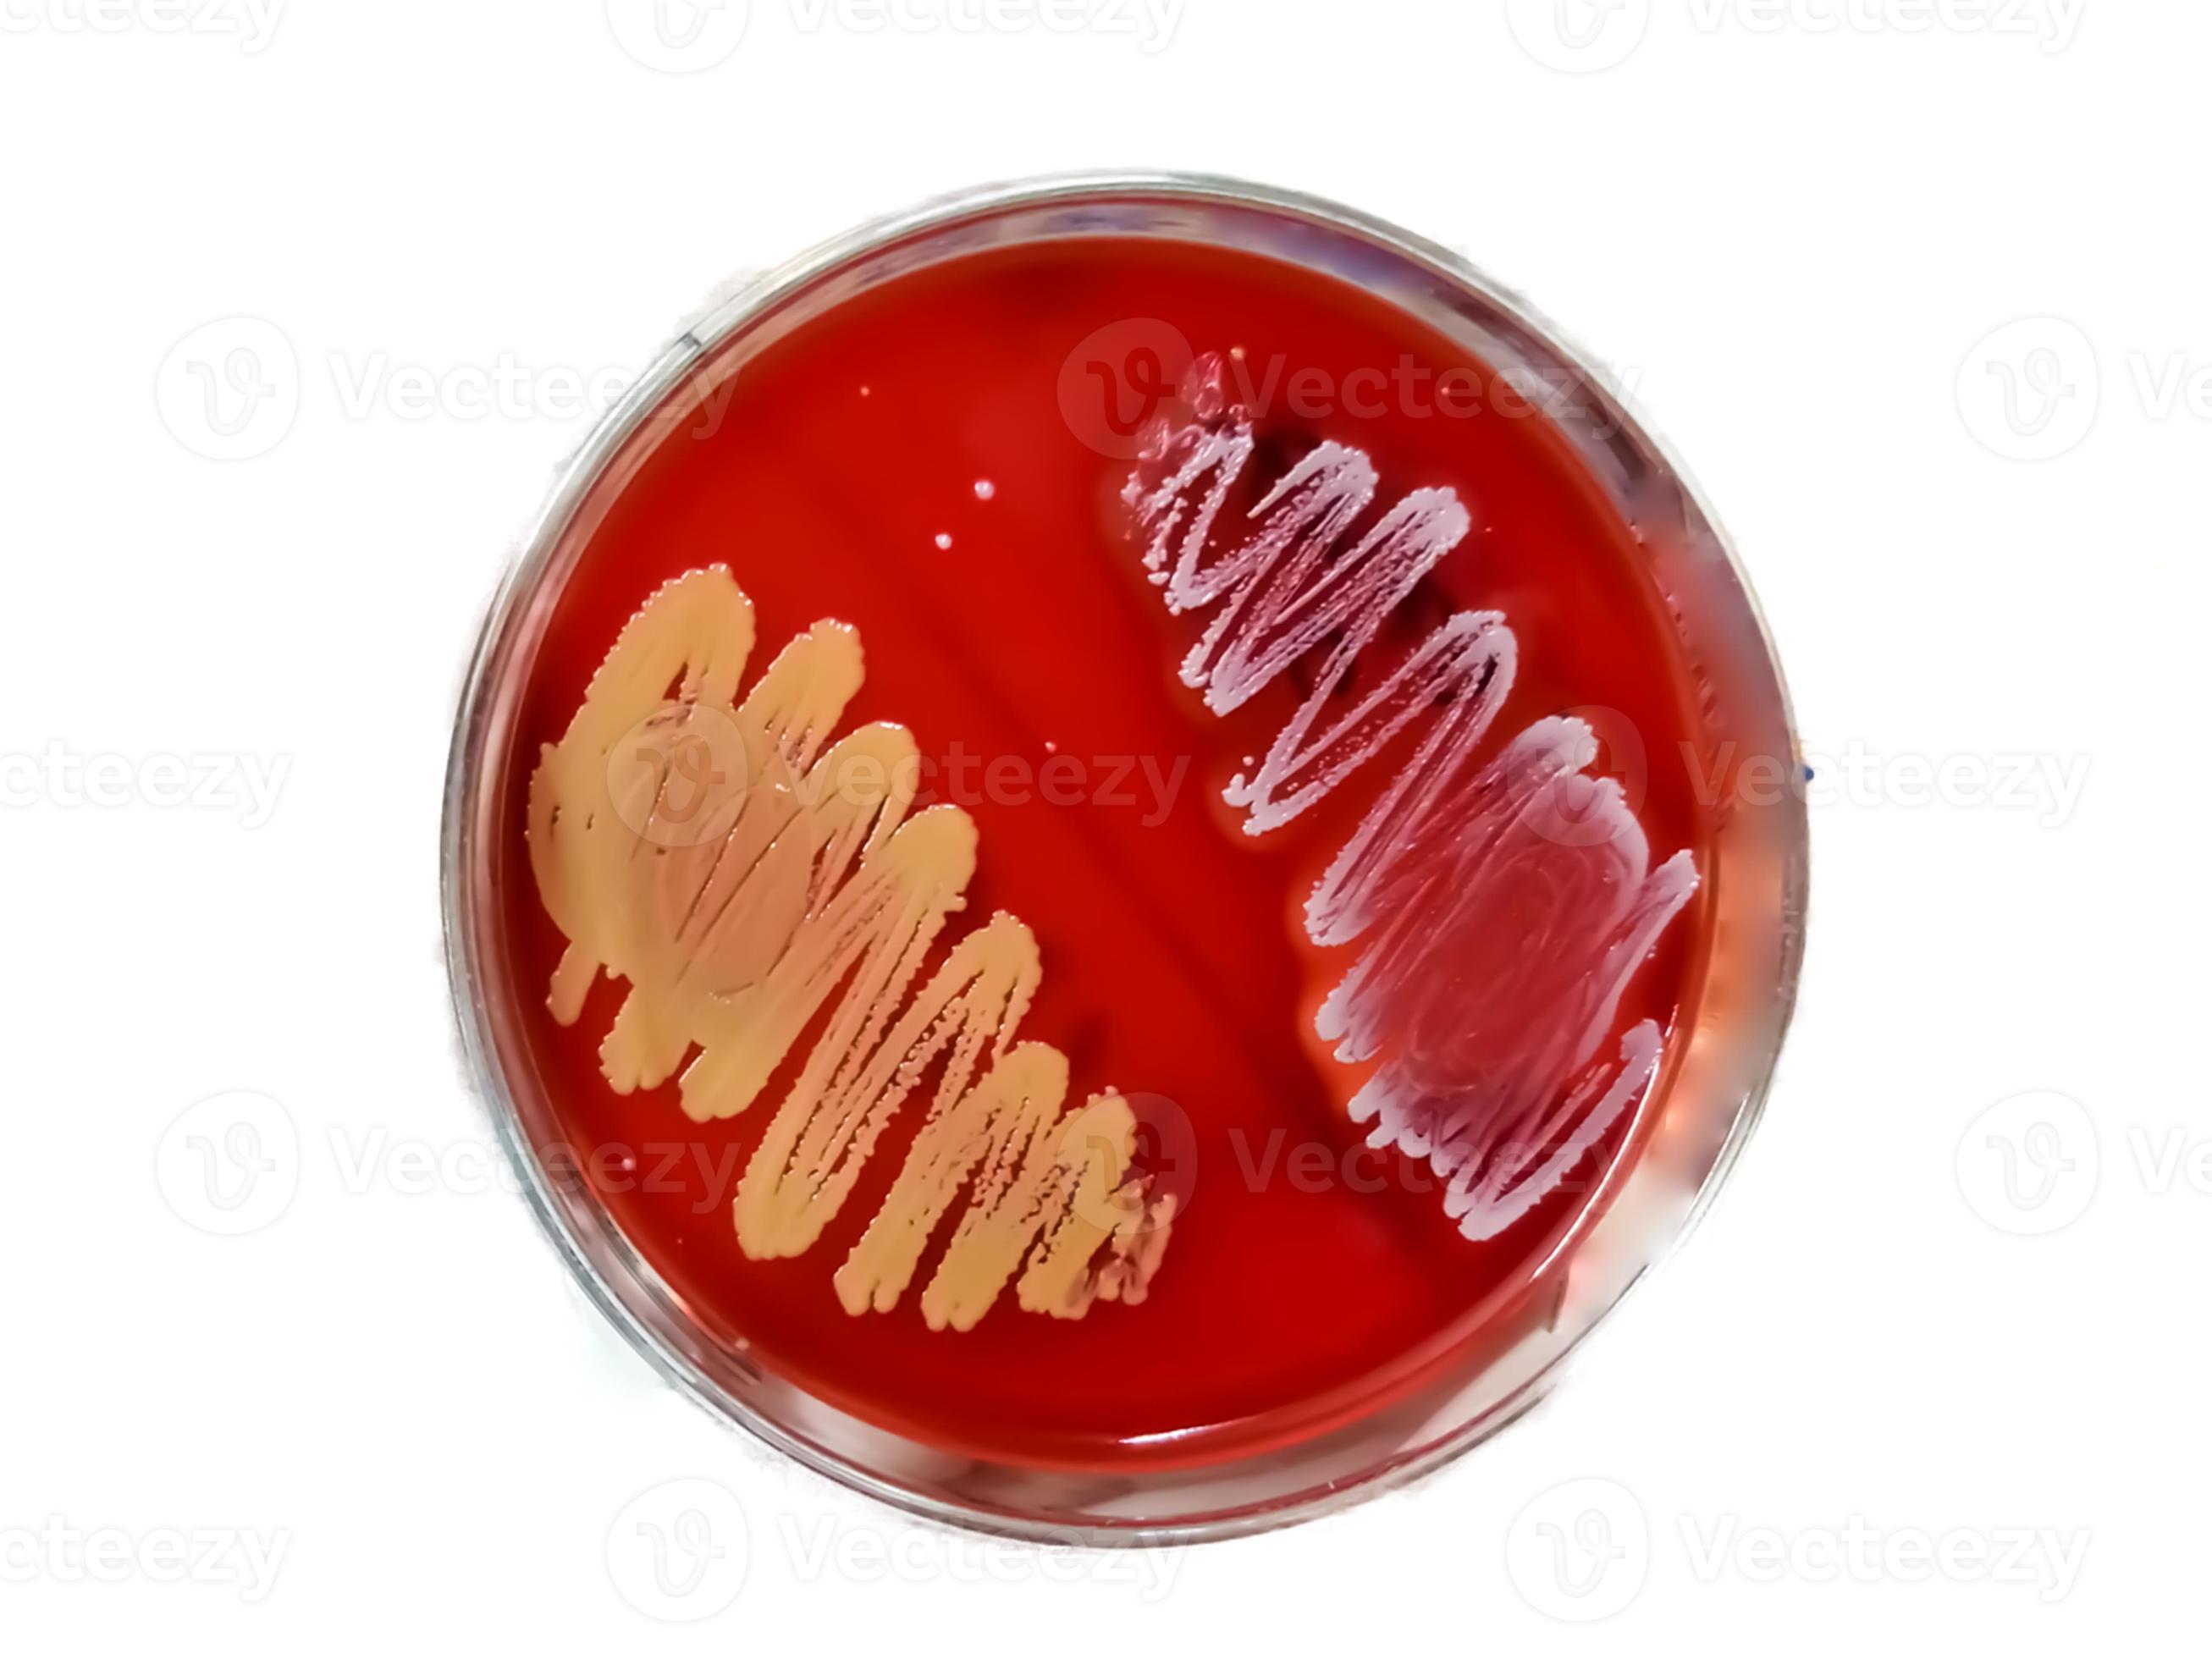

¿Qué es una colonia bacteriana? Las bacterias son organismos microscópicos unicelulares. Para cultivarlas, se deben esparcir sobre una superficie de agar en una placa de Petri que contiene nutrientes necesarios para su crecimiento. Cuando las bacterias se alimentan, se multiplican y forman colonias bacterianas, que son visibles a simple.. Bienvenidos al fascinante mundo del agua, donde la microbiología juega un papel esencial. Aquí, exploraremos juntos qué es una colonia en microbiología, un fenómeno natural que tiene lugar en nuestros cuerpos de agua y es vital para su salud y equilibrio. Prepárate para sumergirte en el microscópico universo de las colonias bacterianas. ¿Estás listo para […]

Esquema de una bacteria ¡Fotos & Guía 2021!

Colonias Bacterianas Así se cuentan en el laboratorio Cromtek

Colonia De Bacterias En Medio De Cultivo Placa Imagen de archivo Imagen de identifique

Bacteriología Concise Medical Knowledge
Micro Gaia Una colonia bacteriana en 3D "Extended Depth of Field"

Colonias de color de las bacterias en placas de Petri Fotografía de stock Alamy

Colonia De Bacterias En Placa Del Medio De Cultivo Foto de archivo Imagen de médico, medicina

Microbiología. Crecimiento de bacterias de colonia en placa de petry, 3 etapas, vector de estilo

Colonia Bacteriana El Patógeno En Una Placa De La Raya Del Agar Foto de archivo Imagen de

Colonia de bacterias en medio de cultivo, Microbiología. 2024

Célula bacteriana qué es, características, estructura (partes)

analisa genoma de bactéria em tempo recorde Galileu Inovação

Cultura Bacteriana Colônias de Bactérias Microbiologia InfoEscola

Colonias Bacterianas Rojas En Una Placa De Petri Aislada En Negro Imagen de archivo Imagen de

Cultura Bacteriana Colônias de Bactérias Microbiologia InfoEscola

Cultura Bacteriana De Las Colonias En Los Medios Selectivos Del Agar (agar De Los SS) Foto de
Uma Colonia De Bacterias Isolada Para Cultura Se Reproduz EDUCA

Colonia De Bacterias En Placa Del Medio De Cultivo Imagen de archivo Imagen de escherichia
colonia bacteriana en agar sangre en placa petri. medios de cultivo bacterianos. microbiólogo

Reino Bacteria características, anatomía y fisiología
Las colonias bacterianas son organismos extremadamente pequeños, que sólo miden algunos micrómetros de tamaño y pueden ser observadas de manera macroscópica. Estas poblaciones de células parten de una sóla célula y crecen en un medio sólido, para cuantificarlas, existe un equipo contador de colonias bacterianas.. En los laboratorios de microbiología, química, biología, bioquímica.. 6. Morfología de las Colonias. Una colonia es una agrupación de bacterias formada a partir de la reproducción de una Unidad Formadora de Colonia (UFC) sobre un medio sólido; aunque varía de tamaño generalmente es visible a simple vista. Una UFC puede ser un solo microorganismo o bien un grupo de microorganismos de una misma especie como.